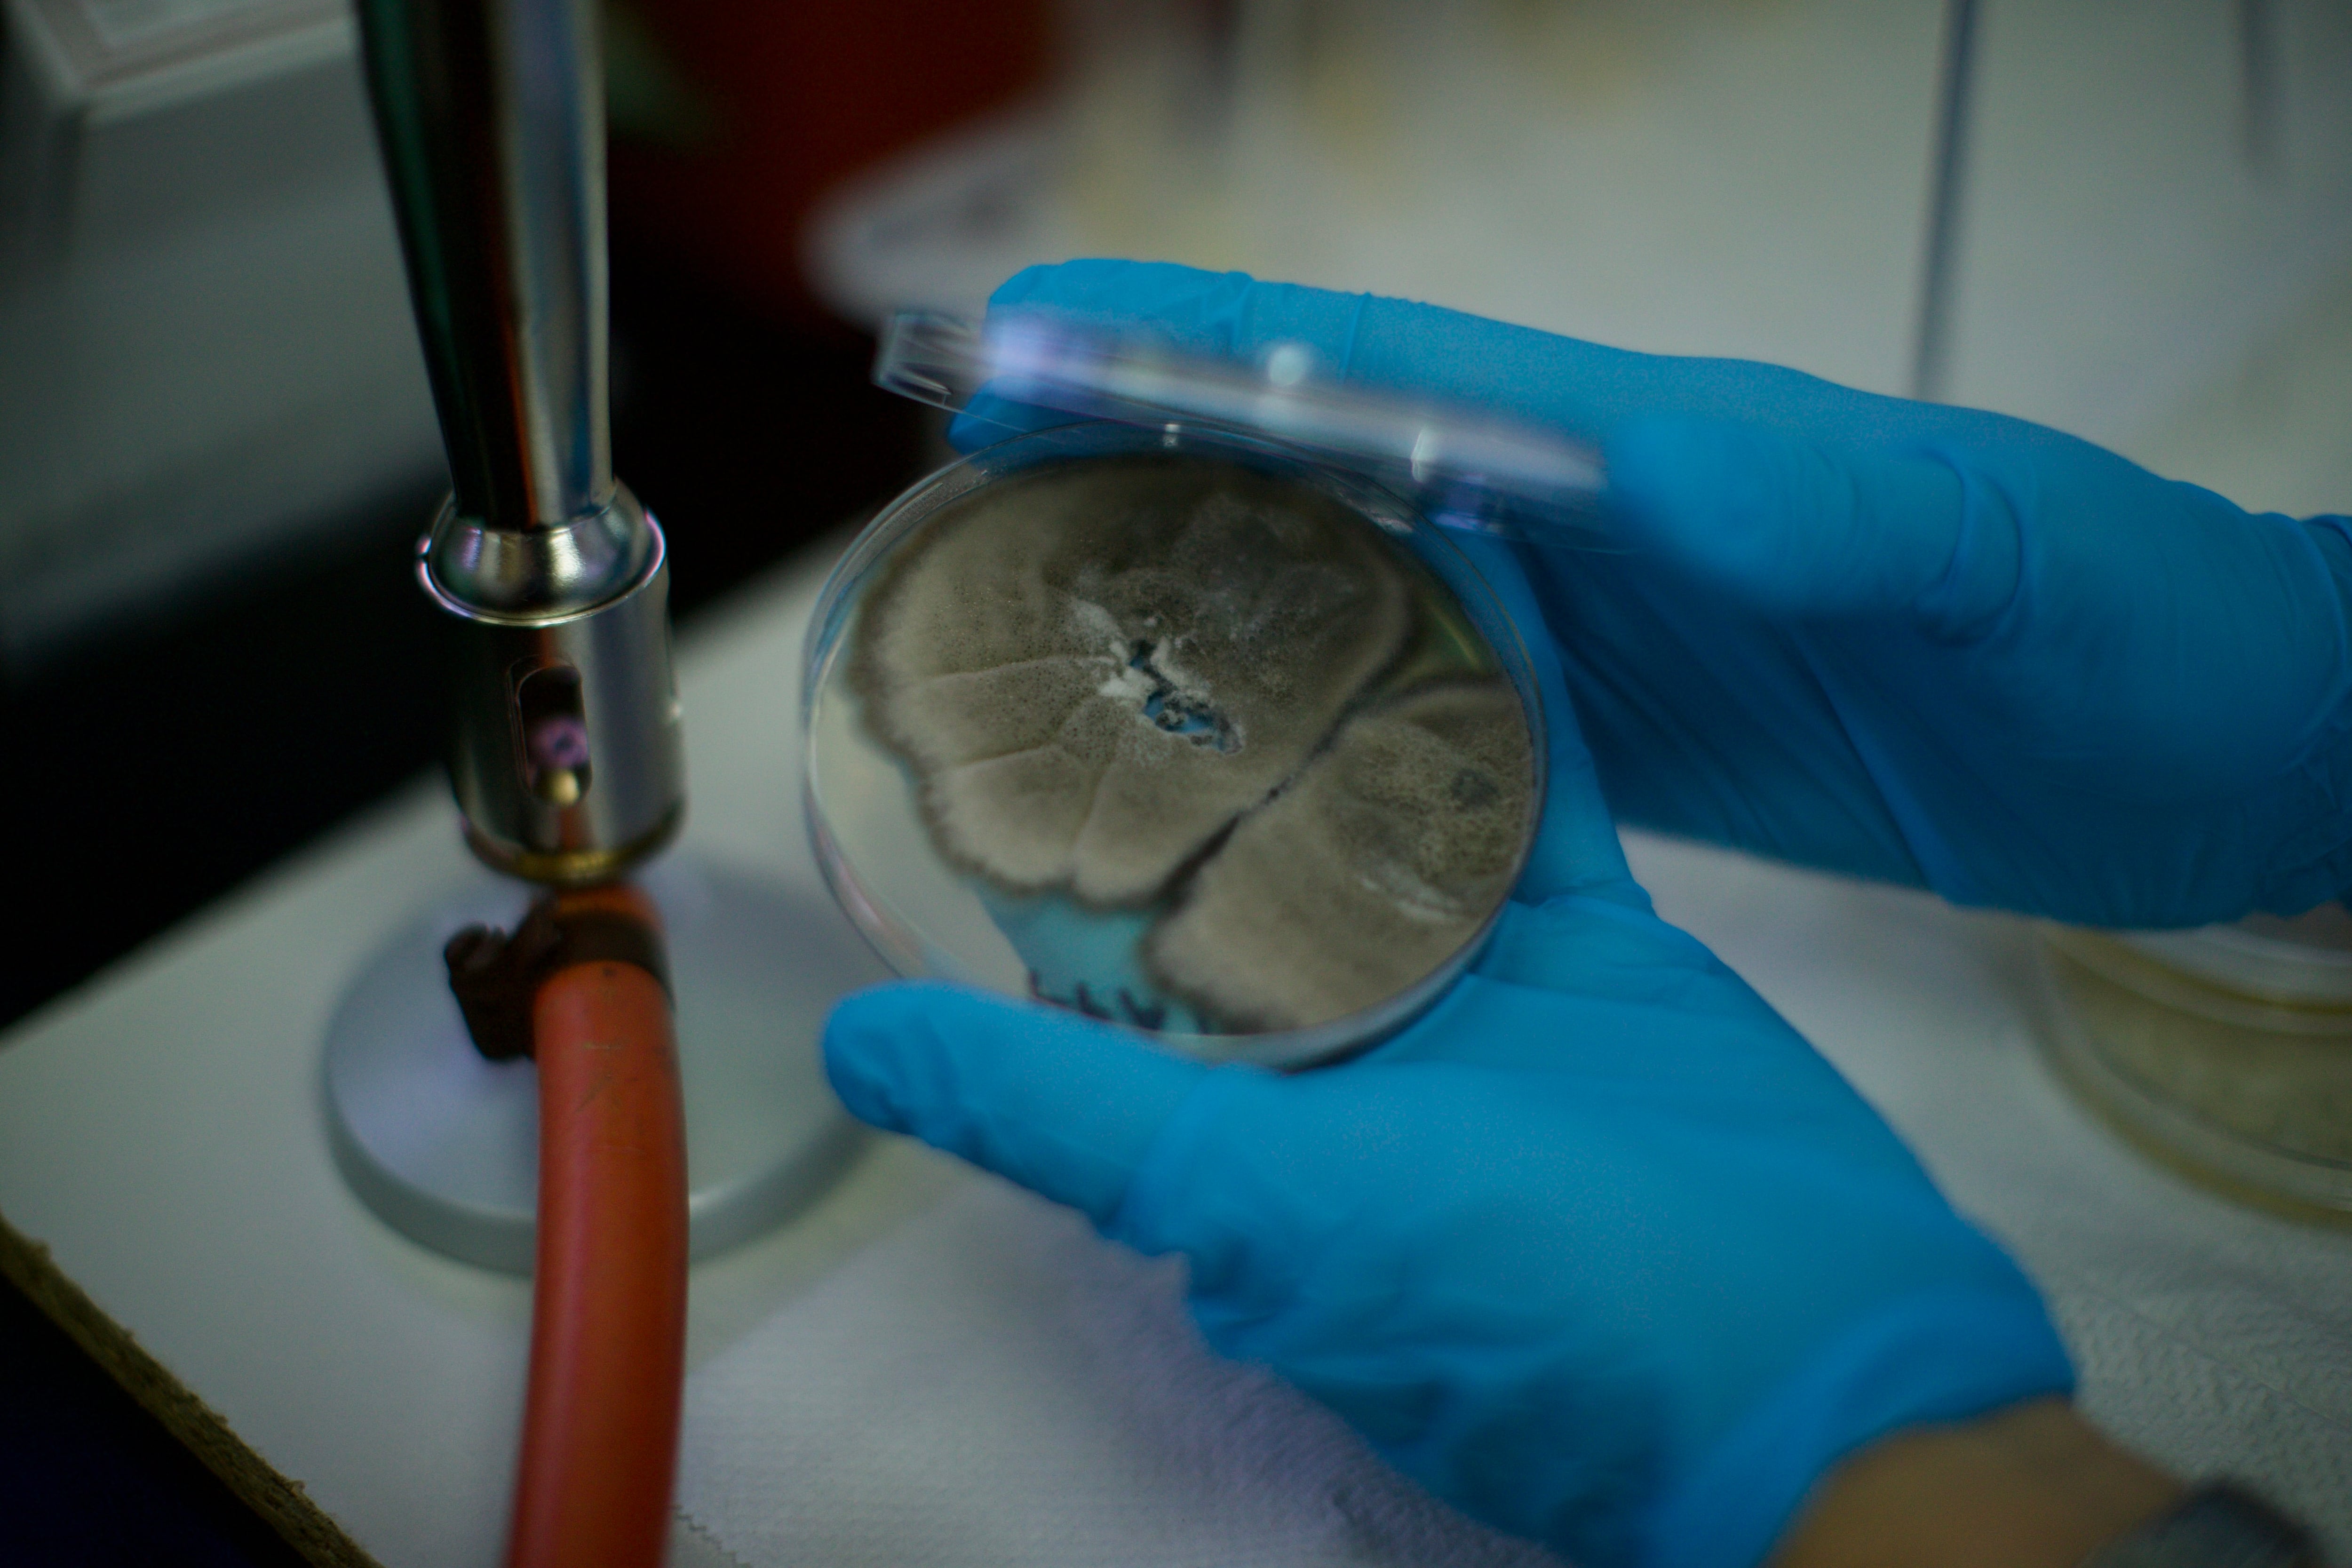

Aquella mañana de miércoles, la Dirección del Teatro Nacional no era el escenario de reuniones administrativas o artísticas. Los que estaban allí reunidos eran profesionales en Física y Microbiología, quienes escudriñaban las paredes para ver más allá de los murales de Paolo Serra, que engalanan las paredes de esa oficina.
A diferencia de otras obras pictóricas del Teatro, estas no eran pinturas sobre un lienzo. Serra viajó desde Italia para pintar sus murales directamente en las paredes del Teatro poco antes de su inauguración, en 1897.
Más de 125 años después, el paso del tiempo y la humedad de un país tropical deterioran poco a poco el arte. Como parte del proceso, bacterias y hongos colonizaron la obra porque, en medio de los pigmentos y otros materiales, encuentran alimentos. ¿Esa convivencia de colonias de microorganismos afecta a las pinturas? ¿Estarían ayudando a un deterioro mayor? ¿Hay forma de frenarlo o de que vaya más lento?
La ciencia se vuelve aliada para determinar cuáles son los daños que se percibían a simple vista en partes de las paredes. Muchas de estas aparecían como manchas blancas en algunas zonas.

Los especialistas en Física, con la ayuda de cortinas y otros implementos, oscurecieron el salón. Solo así podrían saber, con cámaras de luz ultravioleta e infrarroja, cuáles eran las zonas con mayor presencia de estos microorganismos.
“Esto nos permite ver pigmentos o coloraciones que a simple vista no vemos y puede ser una guía para encontrar microorganismos”, detalló el físico Óscar Andrey Herrera Sancho, coordinador del proyecto.
Herrera lidera a un grupo de científicos de diferentes ramas quienes, desde 2016, estudian el deterioro de diversas obras de arte del Teatro para buscar mejores prácticas de conservación. El propósito es claro: que todo lo que la sociedad costarricense ha podido apreciar durante años, pueda seguir siendo apreciado por el mayor número de generaciones posible.
La información dada por las fotografías llevaba a una segunda parte, en la que Alejandra Gómez y Daniela Jaikel Víquez, profesionales en Microbiología, tomaban las riendas para sacar muestras de los diferentes rincones en donde habría mayor presencia de hongos y bacterias.

Con hisopos y equipos, las profesionales tomaron muestras, sea subidas en escaleras o de cuclillas. Lo importante era llegar a los rincones señalados por el examen de luces ultravioletas e infrarrojas (o los que ya eran evidentes a simple vista). Para cada uno de esos sitios de interés se tomaron muestras de un centímetro cuadrado.
Si los lienzos están expuestos a microorganismos que eventualmente pudieran deteriorarlos y afectar su conservación, los murales en las paredes tienen un riesgo añadido, especialmente en las partes que están a la altura de un humano. Jaikel recordó que el arte en mural está más expuesto a ser tocado con las manos, a que personas se apoyen, a que alguien deje algún objeto contra la pared.
“(La oficina) está cerca de la calle, está el ruido de la calle, la contaminación. También, si se cierran las ventanas hay un efecto de concentración. Hay hongos que son de interiores, de sitios de concentración, la presencia podría aumentar en estas condiciones. Y esto no se resuelve con abrir las ventanas, los hongos ahí quedan y van creciendo”, señaló.

Una vez que se tomaron las muestras, estas se pusieron en una hielera para mantener su viabilidad y ser llevadas a los laboratorios universitarios para su análisis.
Toma cerca de una semana que estas crezcan y se reproduzcan lo suficiente como para conocer cuáles microorganismos “viven” en los pigmentos y, con base en eso, saber si puede darse un deterioro. Esto también lleva a los científicos a dar recomendaciones para una mejor conservación.
“Hay herramientas que pueden usarse no solo para preservar las pinturas, sino también para disminuir, por ejemplo, esos nichos donde están colonizando los hongos”, expresó Jaikel.

Los análisis dieron con seis puntos de la pared positivos por diferentes microorganismos.
“En realidad sí teníamos un deterioro bastante grande y era muy notorio a nivel visible. Veíamos esas manchas blancas en la pared, y las pruebas de laboratorio lo demostraron”, destacó Jaikel.
En esta ocasión no solo se identificaron los hongos y bacterias (algo que ya han hecho en otras obras), también se cuantificaron.
“Esto nos permitirá ver, si en un futuro se hace una limpieza, si esta funcionó para reducir cuantitativamente los organismos”, resumió la microbióloga, especialista en hongos.
Los microorganismos
Dentro de los hongos encontrados están los Cladosporium sp. Según explicó la especialista, este es un hongo negro, con alto poder de resistencia a la luz ultravioleta.
Según lo estudiado hasta el momento en otros espacios de este edificio, este es el hongo que más circula en el aire del Teatro Nacional, pero también es de los más comunes en interiores en Costa Rica. En este caso, los hongos de este género se vieron en tres de los seis sitios muestreados.
Los científicos también hallaron Penicillium sp., otro hongo de interiores.
También, como era de esperar, encontraron hongos que son comunes en los seres humanos, como Candida sp. “En algún momento, alguien se apoyó en la pared y dejó ahí sus manos, esto es normal en un recinto como este”, precisó.
Dentro de las bacterias, se encontraron tres: Bacillus cereus, descrita por Jaikel como la “bacteria estrella” en todos los muestreos de pinturas. Según comentó la microbióloga, esta especie tiene la capacidad de hacer esporas de resistencia, lo cual explica por qué puede mantenerse en todas estas obras pictóricas durante tanto tiempo. No necesariamente los pigmentos son fuente de alimentación para esta bacteria, pero las estrategias del microorganismo lo hacen sobrevivir en ambientes hostiles.
También se encontraron Sphingomonas paucimobilis y Staphylococcus saprophyticus. Esta última bacteria también es muy común en los humanos, por lo que también es probable que esté relacionada con el contacto que haya tenido con la piel de algún visitante que tocó la pared.
¿Qué sigue? La investigación de estos científicos ayudará a tomar decisiones para una mejor conservación, ya que se conocen los microorganismos específicos se podrá buscar formas de contrarrestarlos sin que afecten la obra.
Natalia Cordero Villalobos, del Departamento de Conservación del Teatro Nacional, destacó que si se trabaja de la mano con la ciencia, podrán tomarse mejores decisiones para que el arte pueda acompañar a más generaciones y estas puedan disfrutarlo.
En este momento, el foyer del Teatro es sujeto de una restauración por parte de otro grupo de profesionales en restauración.
¿Cómo trabaja la ciencia para conservar el Teatro Nacional?
Pinturas del Teatro Nacional tienen material más antiguo que territorio de Costa Rica
Científicos de Costa Rica descubren nueva especie de hongo en pintura del Teatro Nacional
¿Con qué pigmentos se pintaba hace 120 años? Análisis científico da con uno muy particular en el ‘foyer’ del Teatro Nacional
Tramoya metálica soportará la ‘magia’ del Teatro Nacional
‘Escuela’ de tramoyistas busca preservar labor y heredarla a una nueva generación
La historia detrás del ‘incidente’ que cercenó pie derecho de famosa estatua del Teatro Nacional
Científicos de la UCR ayudan a conservar arte del Teatro Nacional
